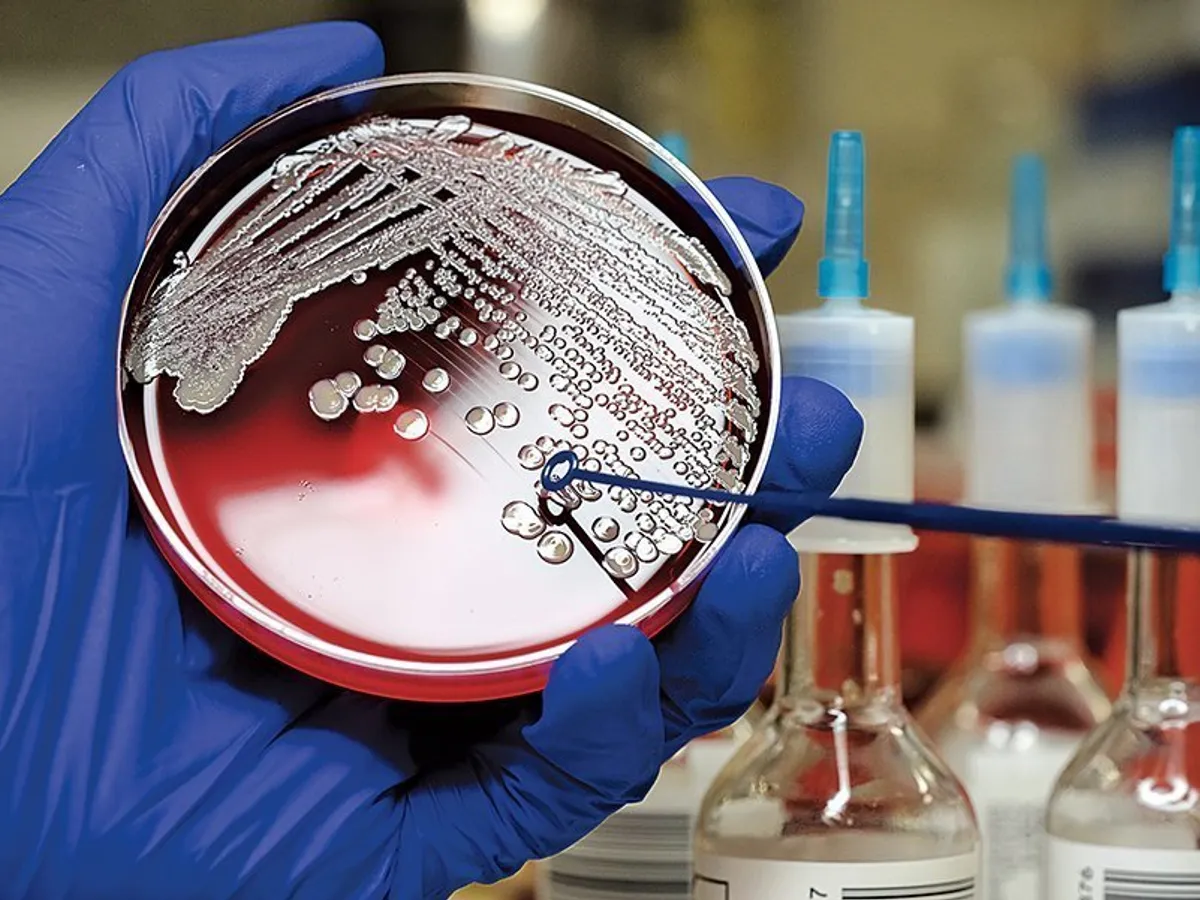

Moartea antibioticelor. Oamenii râmân din nou fără apărare în calea infecțiilor
Data publicării: 28.05.2019 • 22:04
Data actualizării: 31.05.2019 • 09:28

Antibioticele au salvat nenumărate vieți de-a lungul timpului, dar, pe măsură ce bacteriile ucigașe devin rezistente, aceste medicamente minune au încetat să mai funcționeze. Medicina este nevoită să le înlocuiască urgent!
În luna ianuarie, Universitatea Columbia a dat publicității informația potrivit căreia patru pacienți de la Centrul Medical Irving din New York au contractat o variantă neobișnuită de E. coli, o bacterie gastrointestinală altfel des întâlnită.
Articol premium
Contribuie la susținerea jurnalismului de calitate!
Abonamente de la doar 3,50 lei pe săptămână!
Alege tipul de abonament care ți se potrivește!
Abonează-te acum!
__________